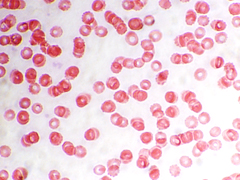
腫瘍細胞のアポトーシスを誘導

フコイダンとは
フコイダンについて
 フコイダンとは、ワカメやコンブ、メカブなどの海藻類のヌメリ成分に多く含まれる天然成分で粘質多糖類の一種です。
フコイダンとは、ワカメやコンブ、メカブなどの海藻類のヌメリ成分に多く含まれる天然成分で粘質多糖類の一種です。
1913年にスウェーデンの学者Kylinによって発見され、「フコイダン」と名付けられました。
このヌメリ成分は、海藻が砂などで傷ついてしまった部分を修復したり、引き潮の時に体が乾燥するのを防いだりする、海藻にとっては大切な成分であり、特にモズクに多く含まれている事がわかっています。
自然治癒力を正常化させる天然成分
 本体を汚れや細菌、ウイルスから守ってくれる成分で、様々な研究が進められる中、人間の防衛機能を回復して免疫力を正常化させるほか、血液凝固抑制作用をはじめ抗腫瘍、血液上昇抑制、中性脂肪抑制、抗アレルギー、肝機能向上作用など、現代人の健康に欠かせない機能が学術的に明らかにされており、本来、人間に備わっている自然治癒力を正常化する効能が明らかになりました。
本体を汚れや細菌、ウイルスから守ってくれる成分で、様々な研究が進められる中、人間の防衛機能を回復して免疫力を正常化させるほか、血液凝固抑制作用をはじめ抗腫瘍、血液上昇抑制、中性脂肪抑制、抗アレルギー、肝機能向上作用など、現代人の健康に欠かせない機能が学術的に明らかにされており、本来、人間に備わっている自然治癒力を正常化する効能が明らかになりました。
代替医療界で最も注目されている天然成分で、化粧品・トイレタリー製品にも利用されています。
最近ではテレビ番組や雑誌などでも取り上げられたりと一般の方にも認知される事となりました。
フコイダンの歴史

- 1913年、スウェーデンの学者kylinによって発見
- 褐藻類のフコイダンは、フコース・キシロース・ガラクトース・ウロン酸等(褐藻によってはマンノースも含む)で構成
- 1996年、第55回日本癌学会において、フコイダンにはがん細胞に選択的に働きかけて自然死に導く(アポトーシス)作用を持つことが発表されて、一躍脚光を浴びる
※がん細胞の遺伝子に働きかけて分裂・増殖をストップさせ自然に死んでしまう
機能を発揮するための条件
トンガ王国産天然モズク

フコイダンは、いくつかの原料由来がありますが主要構成されるフコースなどに顕著な差異は認められていません。しかしながら、とりわけ水質の良い、天然モズクが自生するトンガ王国産モズク由来のフコイダンは最も高含有・高品質・安全なのです。
フコイダンは多糖類の構造(単糖分子が結合された状態)をしており、フコイダンがその機能を発揮するには、一定以上の結合された分子構造(硫酸基)を形成している必要があります。
硫酸基の結合含量13%以上の安定的な形成
 我々の研究によると、フコイダンを形成する結合された分子構造の13%以上の硫酸基が安定的に形成されないとその機能を発揮しないと考えています。
我々の研究によると、フコイダンを形成する結合された分子構造の13%以上の硫酸基が安定的に形成されないとその機能を発揮しないと考えています。
粘膜を保護修復して炎症を抑え、さらに小腸表面にある「腸管免疫」を刺激して免疫力を賦活化するのです。
現在、注目されている素材の一つですが、フコイダンが生理機能を発揮するには、13%以上の硫酸基が結合している必要があると考えています。
海藻のフコイダン含有量
海藻のネバネバ・ヌルヌル成分
| 海藻(乾燥海藻1kgあたり) | 含有量(g) |
|---|---|
| ガゴメコンブ | 40 |
| 真コンブ | 15 |
| ワカメ(葉) | 15 |
| ワカメメカブ(胞子葉) | 80 |
| モズク | 250 |
ネバネバ・ヌルヌルの食べ物は身体に良い、と言われる事が多く、コンブ・ワカメ・モズクなどの海藻は、身近な健康食材として親しまれてきました。
海藻は、ヌルヌルを身にまとうことで、厳しい自然を生き抜いています。
細菌や乾燥などの外敵から身を守るバリア機能、傷ついてしまった部分を修復する自己治癒力を持つネバネバ・ヌルヌルの粘り成分に含まれるのが、フコイダンです。
フコイダンの機能
効果・効能
フコイダンは細胞賦活作用を有し、シワ形成の原因となる細胞同士をつなぎ合わせ肌の弾力性を保つコラーゲン、その間に介在して水分を蓄えるヒアルロン酸の酸化分解を抑制する機能を有しています。また、シミのもととなるメライン色素生成の前駆体(エンドセリン)の働きを阻害する機能があります。さらに、抗アレルギー・抗炎症作用を有しており肌に優しい素材です。
また、血液循環器系改善作用、抗がん・抗転移作用、免疫系改善作用などを有し、生活習慣病の予防に効果を示します。「フコイダン」については、様々な作用が各研究機関により報告されており、特に生活習慣病の予防を目的とした生理作用が研究により明らかにされています。
細胞賦活
肌弾力性保持
肌保水・保湿性維持
抗アレルギー・抗炎症
フコイダンの効能
免疫力賦活化作用
 フコイダンには免疫力賦活化作用があります。人間の自然治癒力を回復・向上して、体質を改善します。アレルギー症状や生活習慣病の予防・改善をすることもわかっています。
フコイダンには免疫力賦活化作用があります。人間の自然治癒力を回復・向上して、体質を改善します。アレルギー症状や生活習慣病の予防・改善をすることもわかっています。
フコイダンは、体内の腸表面の細胞から、血液を通じて全身に伝達されます。また、その際に吸収されなかったフコイダンも、小腸表面を通過するときに「腸管免疫」に刺激を与えることによって免疫力を高めます。
私達の腸には、吸収するべきものとそうでないものを判断して、異物を排出したり中和するという重要な機能が備わっています。消化吸収し、食べ物のカスを便として排出するほか、異物から身体を守る機能もあります。
自分の身体を守る免疫力は、血液中のリンパ球がその中心を担っています。それが小腸や大腸に最も多く存在するので「腸管免疫」と呼ばれています。この部分で異物に対する抗体を作る細胞を刺激し、リンパ管を通じて免疫情報を全身に伝える免疫システムが正常に機能するのをフコイダンは助けてくれます。
免疫システムが上手く働かないと、体内に入ってきた異物を処理できなくなります。食中毒やインフルエンザなどの感染症にかかりやすくなります。また、肌荒れや乾燥、ニキビ、湿疹、口内炎なども誘発しやすくなります。
腫瘍細胞のアポトーシスを誘導
細胞は、個体をよりよい状態に保つために細胞内部であらかじめ決められたプログラムに従って自然死します。これをアポトーシスといいます。
細胞は、個体をよりよい状態に保つために細胞内部であらかじめ決められたプログラムに従って自然死します。これをアポトーシスといいます。
オタマジャクシの尻尾が成長過程でなくなるのも、生理的にコントロールされた細胞の自然死、アポトーシスによるものです。がん細胞やウイルス感染細胞などの危険な細胞もアポトーシスによって腫瘍の成長が未然に防がれていますが、このコントロールに異常が生じると、腫瘍細胞は死ぬことなく増殖していきます。
フコイダンには、腫瘍細胞のアポトーシスを誘導する作用があると言われていましたが、褐藻類に特徴的に含まれるフコキサンチンにアポトーシス誘導作用があることが、近年明らかになりました。フコイダンとして定義されているものには、更にそれぞれの作用が含まれているという事が明らかになってきています。
ピロリ菌の減少による体内の粘膜の保護
 フコイダンは体内の粘膜を保護する役目があります。フコイダンの粘りの素である硫酸基が胃の粘膜を刺激し、胃を活発に動かしてくれます。また、胃潰瘍などの原因のひとつと言われるピロリ菌を減少させます。フコイダンは喉に、胃に、腸管に、粘膜にネバって働きます。
フコイダンは体内の粘膜を保護する役目があります。フコイダンの粘りの素である硫酸基が胃の粘膜を刺激し、胃を活発に動かしてくれます。また、胃潰瘍などの原因のひとつと言われるピロリ菌を減少させます。フコイダンは喉に、胃に、腸管に、粘膜にネバって働きます。
血圧や血清中性脂肪を下げる
 フコイダンは血圧や血清中性脂肪を下げ、サラサラの血液と健康で若々しい血管を維持してくれます。中性脂肪の分解酵素であるリポプロテインリパーゼを活性化させ、血清脂質を低下させるという、悪玉コレステロールを減少させる作用をもっています。
フコイダンは血圧や血清中性脂肪を下げ、サラサラの血液と健康で若々しい血管を維持してくれます。中性脂肪の分解酵素であるリポプロテインリパーゼを活性化させ、血清脂質を低下させるという、悪玉コレステロールを減少させる作用をもっています。
きれいな血液は、動脈硬化や高脂血症、糖尿病などの生活習慣病などの発生を食い止めます。
自然の保水ベールで肌をしっとりとプルプルに
 モズクを洗浄するスタッフから、手がしっとりしてきた、肌がなめらかになってきた、と声があがるようになり、改めてモズクのちからを実感しました。
モズクを洗浄するスタッフから、手がしっとりしてきた、肌がなめらかになってきた、と声があがるようになり、改めてモズクのちからを実感しました。
干潮時に、海面でも干上がってしまわないように水分を体内に蓄える保水作用がしっかりと活きているのです。
フコイダンは、肌にしっかりと結合して肌表面になめらかな保湿保護膜をつくり、乾燥やアレルギー物質による肌への刺激要因から守ります。また、抗酸化作用によって紫外線による弾力成分の劣化を防いだり、損傷治癒作用によってトラブルのないなめらかな肌へ整えられます。
錆びない身体づくり
 フコイダンの原料である褐藻類は、表面のヌメり成分によって自らをガードしています。細菌をよせつけず、強い太陽光や紫外線によって発生する活性酵素をバリアする抗酸化作用をもっています。
フコイダンの原料である褐藻類は、表面のヌメり成分によって自らをガードしています。細菌をよせつけず、強い太陽光や紫外線によって発生する活性酵素をバリアする抗酸化作用をもっています。
加齢とともに体内の抗酸化力は衰え、活性酸素に抵抗できなくなります。過剰な活性酸素は、身体の内側から老化を促進します。血管を固くし、詰まらせ、血流を悪くしたり、紫外線によるシミをつくる原因になります。まさに、身体を錆びさせているのです。
フコイダンの抗酸化作用は、錆びない身体づくりをサポートします。
海中でまもる・地上でまもるフコイダンのちから


フコイダンを選ぶ基準とは
1.フコイダンの含有量

フコイダン業界では、様々なフコイダン製品が販売されています。その数ある製品の中から選ぶ際に、一つの指標となるのがフコイダンの含有量です。
ほとんどの製品にはフコイダン以外の成分も含まれており、製品の内容量とフコイダンを摂取できる量は同じではありません。
2.硫酸基の割合
硫酸基を公表しているフコイダン製品をおすすめします。
関連ページリンク
数値・グラフで見る[フコイダンの研究データ]
フコイダンの各原料(溶液・粉末)の分析結果を掲載しています。
研究実績[フコイダンの研究]
これまで取り組んできた研究実績を紹介しています。
フコイダンQ&A
フコイダンに関するよくあるQ&Aをまとめました。



